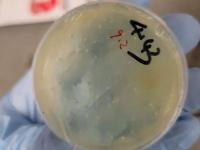
Chinese Scientist From Wuhan Arrested For Smuggling Illegal Biological Material Into US - News | Chinese Scientist From Wuhan Arrested For Smuggling Illegal Biological Material Into US | Latest international News at Lokmattimes.com Chinese Scientist From Wuhan Arrested For Smuggling Illegal Biological Material Into US - News | Chinese Scientist From Wuhan Arrested For Smuggling Illegal Biological Material Into US | Latest international News at Lokmattimes.com

China orders mass testing in Wuhan amid rising COVID-19 cases
By Lokmat English Desk | Updated: August 8, 2021 16:00 IST2021-08-08T16:00:00+5:302021-08-08T16:00:00+5:30

China is once again witnessing a surge in novel coronavirus cases with the spread of the Delta variant.

Last week, authorities in Wuhan, where the disease first emerged in late 2019, announced a mass coronavirus testing for its nearly 12 million residents.

Fearing the spread of the highly transmissible Delta variant, millions of residents have been confined to their homes as cases have been detected in at least 20 cities and several provinces.

State-run media outlet, Xinhua, reported Monday that the country in July recorded 328 new confirmed cases, a number almost equal to China’s total number over the past five months.

The recent surge in cases can be traced back to Nanjing, East China’s Jiangsu province, where cleaners at the Nanjing Lukou International Airport tested positive during routine checking.

A city official blamed “poor sanitisation and protection after disinfecting a plane from Russia” for the infection, news agency Reuters reported.

The city has launched several initiatives to mitigate the spread of the infections such as a mass testing campaign, including three rounds of nucleic acid testing over its nine districts.

According to local media, all flights at the Lukou International Airport have been cancelled since July 30, and anyone leaving Nanjing must present a negative test report.

Zhangjiajie, a city in Central China’s Hunan province, has been recognised as another hotbed of Covid infections, after 10 travelers from Nanjing, who had come to watch a performance, tested positive.

State-run Global Times reported that the popular tourist destination has ordered all residents and tourists to not leave the city. At least 13 confirmed cases have been found till August 3.

Another province in central China, Henan has reported new coronavirus cases. The city of Zhengzhou, which witnessed devastating floods in July, reported 13 locally transmitted confirmed Covid-19 cases and 50 asymptomatic cases.

The municipal authorities of Zhangjiajie, a tourist destination in China's south Hunan province where the new clusters of cases were reported, and spread to 15 Chinese provinces, banned people from leaving the city.

The new infections raised concern over the Chinese vaccines, especially against the Delta variant, as China has administered 1.60 billion doses of the locally-made vaccines so far.

China's top epidemiologist Zhong Nanshan claimed that the Chinese vaccines were effective against the Delta variant.

The Chinese Covid-19 vaccines can protect people against the Delta variant, Zhong said, referencing studies of some 100 patients who were infected with the variant in southern Guangzhou city in May.

Zhong said that to achieve herd immunity through vaccination, China -- which has a population of nearly 1.4 billion -- needs to inoculate 83.3 per cent of its population.